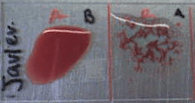

ABO blood group system

The ABO blood group system is the most important blood type system (or blood group system) in human blood transfusion. Found on platelets, epithelium, and cells other than erythrocytes, AB antigens (as with other serotypes) can also cause an adverse immune response to organ transplantation.[1] The associated anti-A and anti-B antibodies are usually IgM antibodies, which are produced in the first years of life by sensitization to environmental substances, such as food, bacteria, and viruses. ABO blood types are also present in some other animals, for example rodents and apes, such as chimpanzees, bonobos, and gorillas.[2]
History of discoveries of the blood types

The ABO blood group system is widely credited to have been discovered by the Austrian scientist Karl Landsteiner, who identified the O, A, and B blood types in 1900.[3] Landsteiner originally described the O blood type as type "C", and in parts of Europe it is rendered as "0" (zero), signifying the lack of A or B antigen. Landsteiner was awarded the Nobel Prize in Physiology or Medicine in 1930 for his work. Alfred von Decastello and Adriano Sturli discovered the fourth type, AB, in 1902.[4]

Due to inadequate communication at the time, it was subsequently found that the Czech serologist Jan Janský had independently pioneered the classification of human blood into four groups in 1907,[5] but Landsteiner's independent discovery had been accepted by the scientific world while Janský remained then in relative obscurity. However, in 1921 an American medical commission acknowledged Janský's classification. Jan Janský is nowadays credited with the first classification of blood into the four types (I, II, III, IV).
Janský's classification remains in use today. In Russia and states of the former USSR blood types O, A, B, and AB are respectively designated I, II, III, and IV.[6] The designation A and B with reference to blood groups was proposed by Ludwik Hirszfeld.
In America, W.L. Moss published his own (very similar) work in 1910.[7]
Ludwik Hirszfeld and E. von Dungern discovered the heritability of ABO blood groups in 1910–11. Felix Bernstein demonstrated the correct blood group inheritance pattern of multiple alleles at one locus in 1924.[8] Watkins and Morgan, in England, discovered that the ABO epitopes were conferred by sugars, to be specific, N-acetylgalactosamine for the A-type and galactose for the B-type.[9][10][11] After much published literature claiming that the ABH substances were all attached to glycosphingolipids, Finne et al. (1978) found that the human erythrocyte glycoproteins contain polylactosamine chains[12] that contains ABH substances attached and represent the majority of the antigens.[13][14][15] The main glycoproteins carrying the ABH antigens were identified to be the Band 3 and Band 4.5 proteins and glycophorin.[16] Later, Yamamoto's group showed the precise glycosyl transferase set that confers the A, B and O epitopes.[17]
Antigens

The central principle of the ABO system is that antigens – in this instance, sugars physically exposed on the exterior of red blood cells – differ between individuals, who have immunological tolerance only toward what occurs in their own bodies. As a result, many humans express isoantibodies – antibodies against isoantigens, natural components present in the bodies of other members of the same species but not themselves. Isoantibodies may be present against the A and/or B antigens in people who do not themselves have the same antigens in their own blood. These antibodies act as haemagglutinins, which cause blood cells to clump and break apart if they carry the foreign antigens. This harsh response, though an adaptive reaction useful against infection, can cause death when large amounts of such cells are encountered after a blood transfusion, a circumstance not encountered in natural selection prior to modern history. Because A and B antigens are chemically modified from a precursor form that is also present in type O individuals, people with type A and B antigens can accept blood from type O individuals.
Anti-A and anti-B antibodies (called isohaemagglutinins), which are not present in the newborn, appear in the first years of life. Anti-A and anti-B antibodies are usually IgM type, which are not able to pass through the placenta to the fetal blood circulation. O-type individuals can produce IgG-type ABO antibodies.
The precursor to the ABO blood group antigens, present in people of all common blood types, is called the H antigen. Individuals with the rare Bombay phenotype (hh) do not express antigen H on their red blood cells. As the H antigen serves as a precursor for producing A and B antigens, the absence of the H antigen means that the individuals also lack A or B antigens as well (similar to O blood group). However, unlike O group, the H antigen is absent, hence the individuals produce isoantibodies to antigen H as well as to both A and B antigens. If they receive blood from someone with O blood group, the anti-H antibodies will bind to the H antigen on the red blood cells ('RBC') of the donor blood and destroy the RBCs by complement-mediated lysis. Therefore, people with Bombay phenotype can receive blood only from other hh donors (although they can donate as though they were type O). Some individuals with the blood group A1 may also be able to produce anti-H antibodies due to the complete conversion of all the H antigen to A1 antigen.
Production of the H antigen, or its deficiency in the Bombay phenotype, is controlled at the H locus on chromosome 19. The H locus is not the same gene as the ABO locus, but it is epistatic to the ABO locus, providing the substrate for the A and B alleles to modify.[19] The H locus contains three exons that span more than 5 kb of genomic DNA, and encodes the fucosyltransferase that produces the H antigen on RBCs. The H antigen is a carbohydrate sequence with carbohydrates linked mainly to protein (with a minor fraction attached to ceramide moiety). It consists of a chain of β-D-galactose, β-D-N-acetylglucosamine, β-D-galactose, and 2-linked, α-L-fucose, the chain being attached to the protein or ceramide.
The ABO locus, which is located on chromosome 9, contains seven exons that span more than 18 kb of genomic DNA. Exon 7 is the largest and contains most of the coding sequence. The ABO locus has three main alleleic forms: A, B, and O. The A allele encodes a glycosyltransferase that bonds α-N-acetylgalactosamine to the D-galactose end of the H antigen, producing the A antigen. The B allele encodes a glycosyltransferase that bonds α-D-galactose to the D-galactose end of the H antigen, creating the B antigen.
In the case of the O allele, when compared to the A allele, exon 6 lacks one nucleotide (guanine), which results in a loss of enzymatic activity. This difference, which occurs at position 261, causes a frameshift that results in the premature termination of the translation and, thus, degradation of the mRNA. This results in the H antigen remaining unchanged in the case of O groups.
The majority of the ABO antigens are expressed on the ends of long polylactosamine chains attached mainly to band 3 protein, the anion exchange protein of the RBC membrane, and a minority of the epitopes are expressed on neutral glycosphingolipid.
Role of ABO antigens in transfusion medicine
For a blood donor and recipient to be ABO-compatible for a transfusion, the recipient must not have Anti-A or Anti-B antibodies that correspond to the A or B antigens on the surface of the donor's red blood cells (since the red blood cells are isolated from whole blood before transfusion, it is unimportant whether the donor blood has antibodies in its plasma). If the antibodies of the recipient's blood and the antigens on the donor's red blood cells do correspond, the donor blood is rejected. On rejection, the recipient may experience Acute hemolytic transfusion reaction (AHTR).
In addition to the ABO system, the Rh blood group system can affect transfusion compatibility. An individual is either positive or negative for the Rh factor; this is denoted by a '+' or '−' after their ABO type. Those with Rh-positive blood can safely receive both Rh-positive and Rh-negative blood, but those with Rh-negative blood should only receive Rh-negative blood. Rh-negative blood is used in emergencies when there is no time to test a person's Rh type. Because of this, the AB+ blood type is referred to as the "universal recipient", as there are neither Anti-B or Anti-A antibodies in its plasma, and can receive both Rh-positive and Rh-negative blood. Similarly, the O− blood type is called the "universal donor"; since its red blood cells have no A or B antigens and are Rh-negative, no other blood type will reject it.
| Donors | |||||||||
|---|---|---|---|---|---|---|---|---|---|
| O− | A− | B− | AB− | O+ | A+ | B+ | AB+ | ||
| Recipients | O− | ✔ | |||||||
| A− | ✔ | ✔ | |||||||
| B− | ✔ | ✔ | |||||||
| AB− | ✔ | ✔ | ✔ | ✔ | |||||
| O+ | ✔ | ✔ | |||||||
| A+ | ✔ | ✔ | ✔ | ✔ | |||||
| B+ | ✔ | ✔ | ✔ | ✔ | |||||
| AB+ | ✔ | ✔ | ✔ | ✔ | ✔ | ✔ | ✔ | ✔ | |
Alteration of ABO antigens for transfusion
In April 2007, an international team of researchers announced in the journal Nature Biotechnology an inexpensive and efficient way to convert types A, B, and AB blood into type O.[20] This is done by using glycosidase enzymes from specific bacteria to strip the blood group antigens from red blood cells. The removal of A and B antigens still does not address the problem of the Rhesus blood group antigen on the blood cells of Rhesus positive individuals, and so blood from Rhesus negative donors must be used. Patient trials will be conducted before the method can be relied on in live situations.
Another approach to the blood antigen problem is the manufacture of artificial blood, which could act as a substitute in emergencies.[21]
Genetics

Blood groups are inherited from both parents. The ABO blood type is controlled by a single gene (the ABO gene) with three types of alleles inferred from classical genetics: i, IA, and IB. The I designation stands for isoagglutinogen, another term for antigen.[22] The gene encodes a glycosyltransferase—that is, an enzyme that modifies the carbohydrate content of the red blood cell antigens. The gene is located on the long arm of the ninth chromosome (9q34).
The IA allele gives type A, IB gives type B, and i gives type O. As both IA and IB are dominant over i, only ii people have type O blood. Individuals with IAIA or IAi have type A blood, and individuals with IBIB or IBi have type B. IAIB people have both phenotypes, because A and B express a special dominance relationship: codominance, which means that type A and B parents can have an AB child. A couple with type A and type B can also have a type O child if they are both heterozygous (IBi,IAi) The cis-AB phenotype has a single enzyme that creates both A and B antigens. The resulting red blood cells do not usually express A or B antigen at the same level that would be expected on common group A1 or B red blood cells, which can help solve the problem of an apparently genetically impossible blood group.[23]
| Blood group inheritance | |||||||
| Blood type | O | A | B | AB | |||
|---|---|---|---|---|---|---|---|
| Genotype | ii (OO) | IAi (AO) | IAIA (AA) | IBi (BO) | IBIB (BB) | IAIB (AB) | |
| O | ii (OO) | O OO OO OO OO |
O or A AO OO AO OO |
A AO AO AO AO |
O or B BO OO BO OO |
B BO BO BO BO |
A or B AO BO AO BO |
| A | IAi (AO) | O or A AO AO OO OO |
O or A AA AO AO OO |
A AA AA AO AO |
O, A, B or AB AB AO BO OO |
B or AB AB AB BO BO |
A, B or AB AA AB AO BO |
| IAIA (AA) | A AO AO AO AO |
A AA AO AA AO |
A AA AA AA AA |
A or AB AB AO AB AO |
AB AB AB AB AB |
A or AB AA AB AA AB | |
| B | IBi (BO) | O or B BO BO OO OO |
O, A, B or AB AB BO AO OO |
A or AB AB AB AO AO |
O or B BB BO BO OO |
B BB BB BO BO |
A, B or AB AB BB AO BO |
| IBIB (BB) | B BO BO BO BO |
B or AB AB BO AB BO |
AB AB AB AB AB |
B BB BO BB BO |
B BB BB BB BB |
B or AB AB BB AB BB | |
| AB | IAIB (AB) | A or B AO AO BO BO |
A, B or AB AA AO AB BO |
A or AB AA AA AB AB |
A, B or AB AB AO BB BO |
B or AB AB AB BB BB |
A, B, or AB AA AB AB BB |
The table above summarizes the various blood groups that children may inherit from their parents.[24][25] Genotypes are shown in the second column and in small print for the offspring: AO and AA both test as type A; BO and BB test as type B. The four possibilities represent the combinations obtained when one allele is taken from each parent; each has a 25% chance, but some occur more than once.
| Blood group inheritance by phenotype only | ||||
| Blood type | O | A | B | AB |
|---|---|---|---|---|
| O | O | O or A | O or B | A or B |
| A | O or A | O or A | O, A, B or AB | A, B or AB |
| B | O or B | O, A, B or AB | O or B | A, B or AB |
| AB | A or B | A, B or AB | A, B or AB | A, B or AB |
Historically, ABO blood tests were used in paternity testing, but in 1957 only 50% of American men falsely accused were able to use them as evidence against paternity.[26] Occasionally, the blood types of children are not consistent with expectations—for example, a type O child can be born to an AB parent—due to rare situations, such as Bombay phenotype and cis AB.[27]
Subgroups
The A blood type contains about 20 subgroups, of which A1 and A2 are the most common (over 99%). A1 makes up about 80% of all A-type blood, with A2 making up almost all of the rest.[28] These two subgroups are not always interchangeable as far as transfusion is concerned, as some A2 individuals produce antibodies against the A1 antigen. Complications can sometimes arise in rare cases when typing the blood.[28]
With the development of DNA sequencing, it has been possible to identify a much larger number of alleles at the ABO locus, each of which can be categorized as A, B, or O in terms of the reaction to transfusion, but which can be distinguished by variations in the DNA sequence. There are six common alleles in white individuals of the ABO gene that produce one's blood type:[29][30]
| A | B | O |
|---|---|---|
| A101 (A1) A201 (A2) |
B101 (B1) | O01 (O1) O02 (O1v) O03 (O2) |
The same study also identified 18 rare alleles, which generally have a weaker glycosylation activity. People with weak alleles of A can sometimes express anti-A antibodies, though these are usually not clinically significant as they do not stably interact with the antigen at body temperature.[31]
Cis AB is another rare variant, in which A and B genes are transmitted together from a single parent.
Distribution and evolutionary history
The distribution of the blood groups A, B, O and AB varies across the world according to the population. There are also variations in blood type distribution within human subpopulations.
In the UK, the distribution of blood type frequencies through the population still shows some correlation to the distribution of placenames and to the successive invasions and migrations including Norsemen, Danes, Saxons, Celts, and Normans who contributed the morphemes to the placenames and the genes to the population.[32]
The two common O alleles, O01 and O02, share their first 261 nucleotides with the group A allele A01.[33] However, unlike the group A allele, a guanosine base is subsequently deleted. A premature stop codon results from this frame-shift mutation. This variant is found worldwide, and likely predates human migration from Africa. The O01 allele is considered to predate the O02 allele.
Some evolutionary biologists theorize that the IA allele evolved first, followed by O (by the deletion of a single nucleotide, shifting the reading frame) and then IB. This chronology accounts for the percentage of people worldwide with each blood type. It is consistent with the accepted patterns of early population movements and varying prevalent blood types in different parts of the world: for instance, B is very common in populations of Asian descent, but rare in ones of Western European descent. Another theory states that there are four main lineages of the ABO gene and that mutations creating type O have occurred at least three times in humans.[34] From oldest to youngest, these lineages comprise the following alleles: A101/A201/O09, B101, O02 and O01. The continued presence of the O alleles is hypothesized to be the result of balancing selection.[34] Both theories contradict the previously held theory that type O blood evolved first.
Origin theories
It is possible that food and environmental antigens (bacterial, viral, or plant antigens) have epitopes similar enough to A and B glycoprotein antigens. The antibodies created against these environmental antigens in the first years of life can cross-react with ABO-incompatible red blood cells that it comes in contact with during blood transfusion later in life. Anti-A antibodies are hypothesized to originate from immune response towards influenza virus, whose epitopes are similar enough to the α-D-N-galactosamine on the A glycoprotein to be able to elicit a cross-reaction. Anti-B antibodies are hypothesized to originate from antibodies produced against Gram-negative bacteria, such as E. coli, cross-reacting with the α-D-galactose on the B glycoprotein.[35]
HIV can be neutralized in in vitro experiments using antibodies against blood group antigens specifically expressed on the HIV-producing cell lines.[36][37]
However, it is more likely that the force driving evolution of allele diversity is simply negative frequency-dependent selection; cells with rare variants of membrane antigens are more easily distinguished by the immune system from pathogens carrying antigens from other hosts. Thus, individuals possessing rare types are better equipped to detect pathogens. The high within-population diversity observed in human populations would, then, be a consequence of natural selection on individuals.[38]
Clinical relevance
The carbohydrate molecules on the surfaces of red blood cells have roles in cell membrane integrity, cell adhesion, membrane transportation of molecules, and acting as receptors for extracellular ligands, and enzymes. ABO antigens are found having similar roles on epithelial cells as well as red blood cells.[39][40]
Bleeding and thrombosis (von Willebrand factor)
The ABO antigen is also expressed on the von Willebrand factor (vWF) glycoprotein,[41] which participates in hemostasis (control of bleeding). In fact, having type O blood predisposes to bleeding,[42] as 30% of the total genetic variation observed in plasma vWF is explained by the effect of the ABO blood group,[43] and individuals with group O blood normally have significantly lower plasma levels of vWF (and Factor VIII) than do non-O individuals.[44][45] In addition, vWF is degraded more rapidly due to the higher prevalence of blood group O with the Cys1584 variant of vWF (an amino acid polymorphism in VWF):[46] the gene for ADAMTS13 (vWF-cleaving protease) maps to the ninth chromosome (9q34), the same locus as ABO blood type. Higher levels of vWF are more common amongst people who have had ischaemic stroke (from blood clotting) for the first time.[47] The results of this study found that the occurrence was not affected by ADAMTS13 polymorphism, and the only significant genetic factor was the person's blood group.
Disease risks
Compared to O group individuals, non-O group (A, AB, and B) individuals have a 14% reduced risk of squamous cell carcinoma and 4% reduced risk of basal cell carcinoma.[48] Conversely, type O blood is associated with a reduced risk of pancreatic cancer.[49][50] The B antigen links with increased risk of ovarian cancer.[51] Gastric cancer has reported to be more common in blood group A and least in group O.[52]
According to Glass, Holmgren, et al., those in the O blood group have an increased risk of infection with cholera, and those O-group individuals who are infected have more severe infections. The mechanisms behind this association with cholera are currently unclear in the literature.[53]
ABO hemolytic disease of the newborn
ABO blood group incompatibilities between the mother and child does not usually cause hemolytic disease of the newborn (HDN) because antibodies to the ABO blood groups are usually of the IgM type, which do not cross the placenta. However, in an O-type mother, IgG ABO antibodies are produced and the baby can potentially develop ABO hemolytic disease of the newborn.
Clinical applications
In human cells, the ABO alleles and their encoded glycosyltransferases have been described in several oncologic conditions.[54] Using anti-GTA/GTB monoclonal antibodies, it was demonstrated that a loss of these enzymes was correlated to malignant bladder and oral epithelia.[55][56] Furthermore, the expression of ABO blood group antigens in normal human tissues is dependent the type of differentiation of the epithelium. In most human carcinomas, including oral carcinoma, a significant event as part of the underlying mechanism is decreased expression of the A and B antigens.[57] Several studies have observed that a relative down-regulation of GTA and GTB occurs in oral carcinomas in association with tumor development.[57][58] More recently, a genome wide association study (GWAS) has identified variants in the ABO locus associated with susceptibility to pancreatic cancer.[59]
Clinical marker
A multi-locus genetic risk score study based on a combination of 27 loci, including the ABO gene, identified individuals at increased risk for both incident and recurrent coronary artery disease events, as well as an enhanced clinical benefit from statin therapy. The study was based on a community cohort study (the Malmo Diet and Cancer study) and four additional randomized controlled trials of primary prevention cohorts (JUPITER and ASCOT) and secondary prevention cohorts (CARE and PROVE IT-TIMI 22).[60]
Pseudoscience
During the 1930s, connecting blood groups to personality types became popular in Japan and other areas of the world.[61] There are some positive science studies.[62][63]
Other popular but unsupported ideas include the use of a blood type diet, claims that group A causes severe hangovers, group O is associated with perfect teeth, and those with blood group A2 have the highest IQs. Scientific evidence in support of these concepts is nonexistent.[64]
See also
References
- ↑ Muramatsu M, Gonzalez HD, Cacciola R, Aikawa A, Yaqoob MM, Puliatti C (2014). "ABO incompatible renal transplants: Good or bad?". WORLD JOURNAL OF TRANSPLANTATION. 4 (1): 18–29. doi:10.5500/wjt.v4.i1.18. PMID 24669364.
- ↑ Maton, Anthea; Jean Hopkins; Charles William McLaughlin; Susan Johnson; Maryanna Quon Warner; David LaHart; Jill D. Wright (1993). Human Biology and Health. Englewood Cliffs, New Jersey, USA: Prentice Hall. ISBN 0-13-981176-1.
- ↑ Landsteiner K (1900). "Zur Kenntnis der antifermentativen, lytischen und agglutinierenden Wirkungen des Blutserums und der Lymphe". Zentralblatt Bakteriologie. 27: 357–62.
- ↑ von Decastello A, Sturli A (1902). "Ueber die Isoagglutinine im Serum gesunder und kranker Menschen". Mfinch med Wschr. 49: 1090–5.
- ↑ Janský J (1907). "Haematologick studie u. psychotiku". Sborn. Klinick (in Czech). 8: 85–139.
- ↑ Erb IH (1 May 1940). "Blood Group Classifications, a Plea for Uniformity". Canadian Medical Association Journal. 42 (5): 418–21. PMC 537907
. PMID 20321693. - ↑ Moss WL (1910). "Studies on isoagglutinins and isohemolysins". Bulletin Johns Hopkins Hospital. 21: 63–70.
- ↑ Crow J (1993). "Felix Bernstein and the first human marker locus". Genetics. 133 (1): 4–7. PMC 1205297
. PMID 8417988. - ↑ Morgan, W. T. J. & Watkins, W. M. Br. Med. Bull. 25, 30–34 (1969)
- ↑ Watkins, W. M. Advances in Human Genetics Vol. 10 (eds Harris, H. & Hirschhorn, K.) 1–136 (Plenum, New York, 1980)
- ↑ Watkins, W. M. & Morgan, W. T. J. Vox Sang. 4, 97−119 (1959).
- ↑ Finne, Krusius, Rauvala, Kekomäki, Myllylä, FEBS left. 89: 111–115(1978)
- ↑ Krusius, Finne, Rauvala, Eur. J. Biochem. 92: 289–300(1978)
- ↑ Järnefelt, Rush, Li, Laine, J. Biol. Chem. 253: 8006–8009(1978)
- ↑ Laine and Rush in Molecular Immunology of Complex Carbohydrates (A. Wu, E. Kabat, Eds.) Plenum Publishing Corporation, N.Y. NY (1988)
- ↑ Finne, Eur. J. Biochem. 104: 181-189 (1980)
- ↑ Yamamoto; et al. (1990). "Molecular genetic basis of the histo-blood group ABO system". Nature. 345: 229–233. doi:10.1038/345229a0.
- ↑ Hara, Atsushi; Imamura, Akihiro; Ando, Hiromune; Ishida, Hideharu; Kiso, Makoto (31 December 2013). "A New Chemical Approach to Human ABO Histo-Blood Group Type 2 Antigens". Molecules. 19 (1): 414–437. doi:10.3390/molecules19010414.
- ↑ Benjamin A. Pierce (2008-02-15). Transmission and Population Genetics. ISBN 978-1-4292-1118-5.
- ↑ Liu, QP; Sulzenbacher G; Yuan H; Bennett EP; Pietz G; Saunders K; Spence J; Nudelman E; Levery SB; White T; Neveu JM; Lane WS; Bourne Y; Olsson ML; Henrissat B; Clausen H (April 2007). "Bacterial glycosidases for the production of universal red blood cells". Nat Biotechnol. 25 (4): 454–64. doi:10.1038/nbt1298. PMID 17401360.
- ↑ BBC
- ↑ Klug, William S.; Cummings, Michael R. (1997). Concepts of Genetics (5th ed.). Upper Saddle River, NJ: Prentice Hall. p. 83. ISBN 0135310628.
- ↑ Yazer M, Olsson M, Palcic M (2006). "The cis-AB blood group phenotype: fundamental lessons in glycobiology". Transfus Med Rev. 20 (3): 207–17. doi:10.1016/j.tmrv.2006.03.002. PMID 16787828.
- ↑ "ABO inheritance patterns". Inheritance patterns of blood groups. Australian Red Cross Blood Service. Retrieved 30 October 2013.
- ↑ "ABO blood group system". Abobloodtypes.webnode.com. Retrieved 2015-02-02.
- ↑ Cited in "Misattributed paternity rates and non-paternity rates".
- ↑ "Understanding genetics". Stanford.
- 1 2 Blood Group A Suptypes, The Owen Foundation. Retrieved 1 July 2008.
- ↑ Seltsam A, Hallensleben M, Kollmann A, Blasczyk R (2003). "The nature of diversity and diversification at the ABO locus". Blood. 102 (8): 3035–42. doi:10.1182/blood-2003-03-0955. PMID 12829588.
- ↑ Ogasawara K; Bannai M; Saitou N; et al. (1996). "Extensive polymorphism of ABO blood group gene: three major lineages of the alleles for the common ABO phenotypes". Human Genetics. 97 (6): 777–83. doi:10.1007/BF02346189. PMID 8641696.
- ↑ Shastry, S; Bhat, S (October 2010). "Imbalance in A2 and A2B phenotype frequency of ABO group in South India". Blood Transfusion. 8 (4): 267–270. doi:10.2450/2010.0147-09. PMC 2957492
. PMID 20967168. - ↑ Potts, WTW (1979). "History and Blood Groups in the British Isles". In Sawyer PH. English Medieval Settlement. St. Martin's Press. ISBN 0-7131-6257-0.
- ↑ Cserti, CM; Dzik, WH (2007). "The ABO blood group system and Plasmodium falciparum malaria". Blood. 110 (7): 2250–2258. doi:10.1182/blood-2007-03-077602.
- 1 2 Calafell, Francesc; et al. (September 2008). "Evolutionary dynamics of the human ABO gene". Human Genetics. 124 (2): 123–135. doi:10.1007/s00439-008-0530-8. PMID 18629539. Retrieved 24 September 2008.
- ↑ Jan Van Oss, Carel (2004). "Letter to the Editor: "Natural" Versus Regular Antibodies". The Protein Journal. 23 (6): 357; author reply 359–60. doi:10.1023/B:JOPC.0000039625.56296.6e. PMID 15517982.
- ↑ Arendrup, M; Hansen JE; Clausen H; Nielsen C; Mathiesen LR; Nielsen JO (April 1991). "Antibody to histo-blood group A antigen neutralizes HIV produced by lymphocytes from blood group A donors but not from blood group B or O donors". AIDS. 5 (4): 441–4. doi:10.1097/00002030-199104000-00014. PMID 1711864.
- ↑ Neil, SJ; McKnight A; Gustafsson K; Weiss RA (2005-06-15). "HIV-1 incorporates ABO histo-blood group antigens that sensitize virions to complement-mediated inactivation". Blood. 105 (12): 4693–9. doi:10.1182/blood-2004-11-4267. PMID 15728127.
- ↑ Seymour, R. M.; Allan, M. J.; Pomiankowski, A; Gustafsson, K (2004). "Evolution of the human ABO polymorphism by two complementary selective pressures". Proceedings of the Royal Society B: Biological Sciences. 271 (1543): 1065–1072. doi:10.1098/rspb.2004.2674. PMC 1691687
. PMID 15293861. - ↑ Reid, ME; Mohandas, N (2004). "Red blood cell blood group antigens: structure and function.". Seminars in hematology. 41 (2): 93–117. doi:10.1053/j.seminhematol.2004.01.001. PMID 15071789.
- ↑ Mohandas, N; Narla, A (2005). "Blood group antigens in health and disease.". Current Opinion in Hematology. 12 (2): 135–40. doi:10.1097/01.moh.0000153000.09585.79. PMID 15725904.
- ↑ Sarode, R; Goldstein J; Sussman II; Nagel RL; Tsai HM (June 2000). "Role of A and B blood group antigens in the expression of adhesive activity of von Willebrand factor". Br J Haematol. 109 (4): 857–64. doi:10.1046/j.1365-2141.2000.02113.x. PMID 10929042.
- ↑ O'Donnell, J; Laffan MA (August 2001). "The relationship between ABO histo-blood group, factor VIII and von Willebrand factor". Transfus Med. 11 (4): 343–51. doi:10.1046/j.1365-3148.2001.00315.x. PMID 11532189.
- ↑ O'Donnell, J; Boulton FE; Manning RA; Laffan MA (2002-02-01). "Amount of H antigen expressed on circulating von Willebrand factor is modifiedby ABO blood group genotype and is a major determinant of plasma von Willebrand factor antigen levels". Arterioscler Thromb Vasc Biol. American Heart Association, Inc. 22 (2): 335–41. doi:10.1161/hq0202.103997. PMID 11834538.
- ↑ Gill, JC; Endres-Brooks J; Bauer PJ; Marks WJ; Montgomery RR (June 1987). "The effect of ABO blood group on the diagnosis of von Willebrand disease" (abstract). Blood. 69 (6): 1691–5. PMID 3495304.
- ↑ Shima, M; Fujimura Y; et al. (1995). "ABO blood group genotype and plasma von Willebrand factor in normal individuals". Vox Sang. 68 (4): 236–40. doi:10.1111/j.1423-0410.1995.tb02579.x. PMID 7660643.
- ↑ Bowen, DJ; Collins PW; et al. (March 2005). "The prevalence of the cysteine1584 variant of von Willebrand factor is increased in type 1 von Willebrand disease: co-segregation with increased susceptibility to ADAMTS13 proteolysis but not clinical phenotype". Br J Haematol. Blackwell Synergy. 128 (6): 830–6. doi:10.1111/j.1365-2141.2005.05375.x. PMID 15755288.
- ↑ Bongers T; de Maat M; van Goor M; et al. (2006). "High von Willebrand factor levels increase the risk of first ischemic stroke: influence of ADAMTS13, inflammation, and genetic variability". Stroke. 37 (11): 2672–7. doi:10.1161/01.STR.0000244767.39962.f7. PMID 16990571.
- ↑ Xie J, Qureshi AA, Li Y, Han J (2010). "ABO Blood Group and Incidence of Skin Cancer". PLoS ONE. 5 (8): e11972. Bibcode:2010PLoSO...511972X. doi:10.1371/journal.pone.0011972.
- ↑ Wolpin, B. M.; Kraft, P.; Gross, M.; Helzlsouer, K.; Bueno-De-Mesquita, H. B.; Steplowski, E.; Stolzenberg-Solomon, R. Z.; Arslan, A. A.; Jacobs, E. J.; Lacroix, A.; Petersen, G.; Zheng, W.; Albanes, D.; Allen, N. E.; Amundadottir, L.; Anderson, G.; Boutron-Ruault, M. -C.; Buring, J. E.; Canzian, F.; Chanock, S. J.; Clipp, S.; Gaziano, J. M.; Giovannucci, E. L.; Hallmans, G.; Hankinson, S. E.; Hoover, R. N.; Hunter, D. J.; Hutchinson, A.; Jacobs, K.; Kooperberg, C. (2010). "Pancreatic Cancer Risk and ABO Blood Group Alleles: Results from the Pancreatic Cancer Cohort Consortium". Cancer Research. 70 (3): 1015–1023. doi:10.1158/0008-5472.CAN-09-2993. PMC 2943735
. PMID 20103627. - ↑ Amundadottir, L.; Kraft, P.; Stolzenberg-Solomon, R. Z.; Fuchs, C. S.; Petersen, G. M.; Arslan, A. A.; Bueno-De-Mesquita, H. B.; Gross, M.; Helzlsouer, K.; Jacobs, E. J.; Lacroix, A.; Zheng, W.; Albanes, D.; Bamlet, W.; Berg, C. D.; Berrino, F.; Bingham, S.; Buring, J. E.; Bracci, P. M.; Canzian, F.; Clavel-Chapelon, F. O.; Clipp, S.; Cotterchio, M.; De Andrade, M.; Duell, E. J.; Fox Jr, J. W.; Gallinger, S.; Gaziano, J. M.; Giovannucci, E. L.; Goggins, M. (2009). "Genome-wide association study identifies variants in the ABO locus associated with susceptibility to pancreatic cancer". Nature Genetics. 41 (9): 986–990. doi:10.1038/ng.429. PMC 2839871
. PMID 19648918. - ↑ Gates, MA; Wolpin, BM; Cramer, DW; Hankinson, SE; Tworoger, SS (2010). "ABO blood group and incidence of epithelial ovarian cancer". International Journal of Cancer. Journal International Du Cancer. 128 (2): 482–486. doi:10.1002/ijc.25339. PMC 2946962
. PMID 20309936. - ↑ Aird, I; Bentall, HH; Roberts, JA (1953). "A relationship between cancer of stomach and the ABO blood groups". British Medical Journal. 1 (4814): 799–801. doi:10.1136/bmj.1.4814.799. PMC 2015995
. PMID 13032504. - ↑ Glass, Roger; Holmgren J; Haley C; Khan M.R.; SVENERHOLM M; STOLL B; HOSSAIN K; BLACK B; Yunus M; Barua D (June 1985). "Predisposition for cholera of individuals with O blood group. Possible evolutionary significance". American Journal of Epidemiology. 121 (6): 791–796. PMID 4014172. Retrieved 20 August 2012.
- ↑ Goldman, M (2016-10-10). "Translational Mini-Review Series on Toll-like Receptors: Toll-like receptor ligands as novel pharmaceuticals for allergic disorders". Clinical and Experimental Immunology. 147 (2): 208–216. doi:10.1111/j.1365-2249.2006.03296.x. ISSN 0009-9104. PMC 1810467
. - ↑ Kay, H E (1982-11-06). "Bone marrow transplantation: 1982.". British Medical Journal (Clinical research ed.). 285 (6351): 1296–1298. ISSN 0267-0623. PMC 1500229
. - ↑ Hakomori, S. (1999-12-06). "Antigen structure and genetic basis of histo-blood groups A, B and O: their changes associated with human cancer". Biochimica Et Biophysica Acta. 1473 (1): 247–266. ISSN 0006-3002. PMID 10580143.
- 1 2 Dabelsteen, E.; Gao, S. (2005-01-01). "ABO blood-group antigens in oral cancer". Journal of Dental Research. 84 (1): 21–28. ISSN 0022-0345. PMID 15615870.
- ↑ Dabelsteen, Erik (2002-02-01). "ABO blood group antigens in oral mucosa. What is new?". Journal of Oral Pathology & Medicine: Official Publication of the International Association of Oral Pathologists and the American Academy of Oral Pathology. 31 (2): 65–70. ISSN 0904-2512. PMID 11896825.
- ↑ Amundadottir, Laufey T. (2016-01-01). "Pancreatic Cancer Genetics". International Journal of Biological Sciences. 12 (3): 314–325. doi:10.7150/ijbs.15001. ISSN 1449-2288. PMID 26929738.
- ↑ Mega, Jessica L.; Stitziel, Nathan O.; Smith, J. Gustav; Chasman, Daniel I.; Caulfield, Mark J.; Devlin, James J.; Nordio, Francesco; Hyde, Craig L.; Cannon, Christopher P. (2015-06-06). "Genetic risk, coronary heart disease events, and the clinical benefit of statin therapy: an analysis of primary and secondary prevention trials". Lancet (London, England). 385 (9984): 2264–2271. doi:10.1016/S0140-6736(14)61730-X. ISSN 1474-547X. PMID 25748612.
- ↑ American Red Cross, Southern California Blood Services Region (n.d.). "Answers to Commonly Asked Questions About Blood and Blood Banking" (PDF). Blood: the Basics: 4. Archived (PDF) from the original on 29 November 2007. Retrieved 16 November 2007.
- ↑ Sung Il Ryu, Young Woo Sohn (2007), A Review of Sociocultural, Behavioral, Biochemical Analyses on ABO Blood-Groups Typology, The Korean Journal of Social and Personality Psychology.
- ↑ Hobgood, Donna K. (2011). "Personality traits of aggression-submissiveness and perfectionism associate with ABO blood groups through catecholamine activities". Medical Hypotheses. 77 (2): 294–300. doi:10.1016/j.mehy.2011.04.039.
- ↑ Klein, Harvey G (7 March 2005). "Why Do People Have Different Blood Types?". Scientific American. Retrieved 16 November 2007.
Further reading
- Dean L (2005). "Chapter 5: The ABO blood group.". Blood Groups and Red Cell Antigens. Retrieved 24 March 2007.
- Farr A (1 April 1979). "Blood group serology--the first four decades (1900--1939)". Med Hist. 23 (2): 215–26. doi:10.1017/s0025727300051383. PMC 1082436
. PMID 381816.
External links
- ABO at BGMUT Blood Group Antigen Gene Mutation Database at NCBI, NIH
- ABO blood groups, antibodies and antigens explained YouTube educational video
- Encyclopaedia Britannica, ABO blood group system
- National Blood Transfusion Service
- Molecular Genetic Basis of ABO